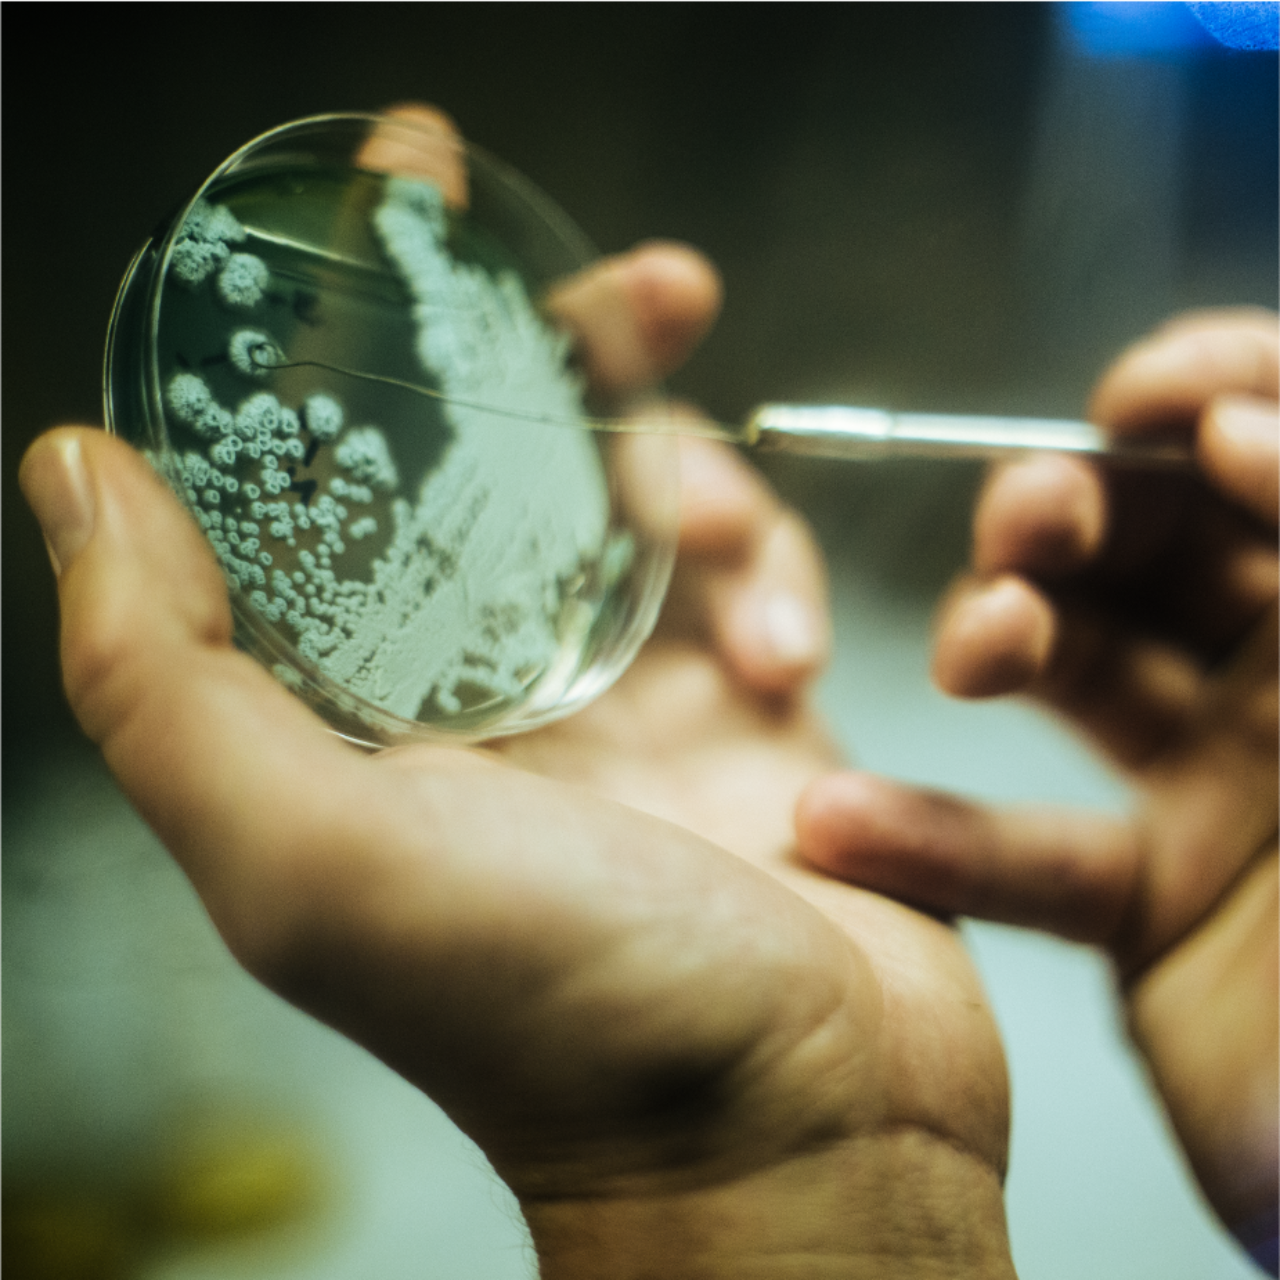
This image needs an alt tag.

ColdFire Brewing
Brewing at the intersections of art and chemistry, European traditions and Northwest flavors
ColdFire was born in 2016 when brothers and homebrewers Dan and Stephen Hughes decided to turn their love of craft beer into their livelihood — and we’ve been lucky enough to have worked with ColdFire before it even had a name. To get this venture off the ground, we first needed to find the right foundation for the brand and literally the right foundation for the first physical location. We went on to choose a name befitting the vision, helped shore up the business model for long-term success, and found a location that we could design into a space that would allow Stephen and Dan to comfortably work their magic. Later came signage, packaging, and events that organically pulled in all of the intersections of their local community.